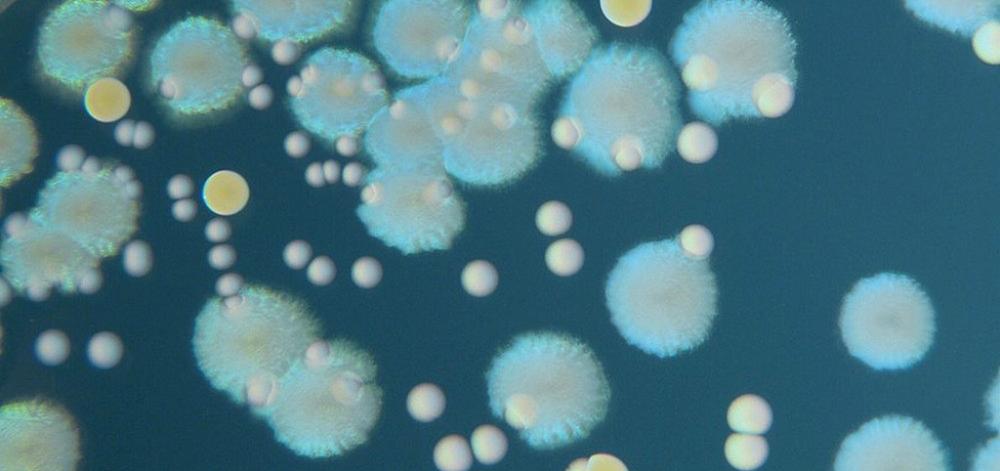

Events
Busca eventos
Past Events


Urban Ecosystem: from Research to Operational Earth Observation
Speaker Jordi Corbera (ICGC) Research, Urban Planning, Environment and Health
Climate change, urban heat island and health in the Barcelona Metropolitan Area
Speaker Javier Martín Vide (UB) Research, Urban Planning, Environment and Health
Land-use, Transport and Population Health: Estimating the Health Benefits of Compact Cities
Speaker Mark Stevenson (University of Melbourne) Research, Urban Planning, Environment and Health
Risk Assessment for Industrially Contaminated Sites
Speakers Manolis Kogevinas (ISGlobal) & Mercè Girona (CEPA-EdC, ARC) Research
Linkages Between Climate Variability, Predictability, Impacts and Services
Speaker Joan Ballester (ISGlobal) Research
Enfermedad Renal Crónica en Centroamérica
Speakers Oriana Ramírez, Javier Sancho & Cristina O' Callaghan (ISGlobal) Research, Translation and Impact
Jornada informativa Smart-Snack para jóvenes y familias sobre los efectos de la dieta en la salud
Speaker Jordi Júlvez (ISGlobal) Emili Ros (IDIBAPS) Research
Assessment of Quality of Life from a Feminist Approach
Speaker Blanca Gutiérrez Valdivia (UPC) Research
Facebook Live with Jordi Sunyer on "Air Pollution and Health"
Speaker Jordi Sunyer (ISGlobal) Research, Urban Planning, Environment and Health
Current and Projected Temperature-Related Morbidity and Mortality in the US: From Attributable Number to Prevention
Speaker Gregory A. Wellenius (Brown University) Research
GCAT, Genomes for Life. A Genome Catalan Population Based Cohort
Speaker Rafael de Cid (IGTP) Research
Adverse Effects on Immune System Functions
Speaker Philippe Grandjean (Harvard University) Research
Arterial Hypertension: The Largest Global Silent Killer
Speakers Xavier de las Cuevas (Consorci Sanitari de Terrassa) & Jordi Serrano (WHO Consultant) Research
Workshop “Nature to Plan Healthy and Equitable Urban Settlements”
Research, Urban Planning, Environment and Health
Plasmodium vivax and Exosomes: Is There a Link?
Speaker Hernando del Portillo (ICREA Research Professor at ISGlobal) Research, Malaria Elimination
Reducing Attrition in the HIV Care Cascade
Speaker Elisa López-Varela (ISGlobal) Research
Discovery of Novel Biomarkers to Improve Antimicrobial Stewardship in Developing Countries
Speaker Climent Casals (ISGlobal) Research
Prenatal Exposure to Perfluoroalkyl Substances and Childhood Growth and Cardio-Metabolic Health
Speaker Cyntia B. Manzano (ISGlobal) Research, Urban Planning, Environment and Health
Transcriptomical Responses to Air and Water Pollution: the EXPOsOMICS Project
Speaker Almudena Espín (Maastricht University) Research, Urban Planning, Environment and Health
Genetically Modified Plants: History, Use and Risk Analysis
Speakers Pere Puigdomènech & Pep Casacuberta (CSIC & CRAG) Research
International Conference on Transport and Health 2017
Research, Translation and Impact, Urban Planning, Environment and Health
Encuentro de los grupos de interés del proyecto BlueHealth: interacciones entre los espacios azules y la salud
Research, Urban Planning, Environment and Health




